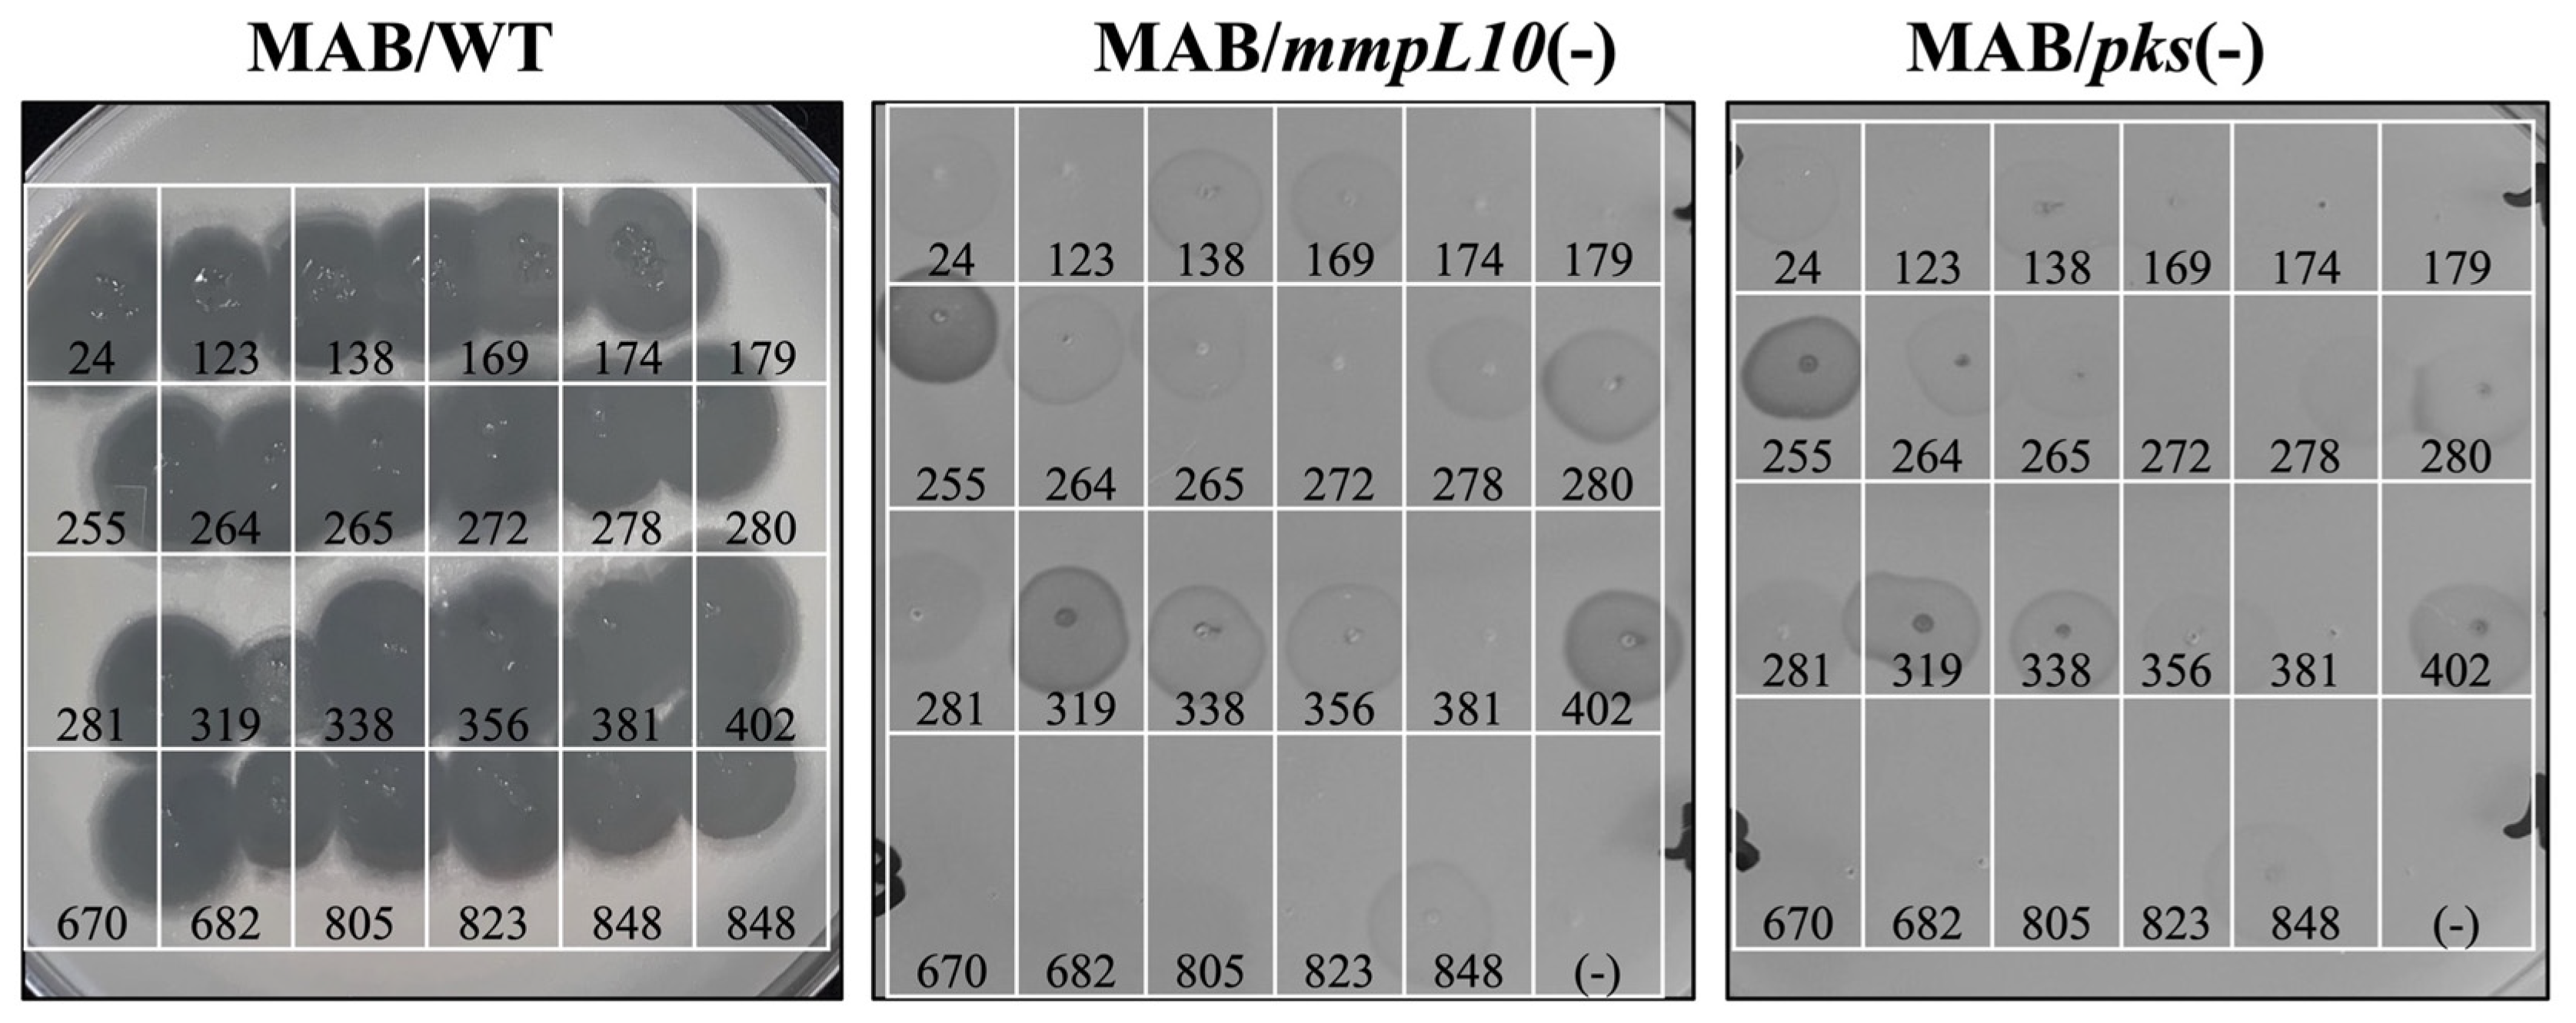
Antibiotics 13 01009 g008

1. Introduction
Mycobacterium avium subsp.
paratuberculosis (MAP) is a highly prevalent and contagious infection in dairy cows, commonly referred to as Johne’s disease. Due to MAP broad geographic spread in nearly every country, it poses a global threat to farmers. While the early infection stages of Johne’s disease make MAP diagnosis very difficult, the economic trade and distribution of silently infected animals further contribute to MAP dissemination in healthy herds. It is estimated that in the dairy industry, approximately 68% of herds are affected with Johne’s disease, and the economic loss due to increased cow replacement costs and reduction in milk production is estimated to be as high as
$1.5 billion annually in the United States alone [
1,
2]. Additionally, while Crohn’s disease in humans is traditionally viewed as autoimmune in nature, mounting evidence suggests that it might have an infectious etiology, with MAP being implicated [
3,
4,
5,
6,
7]. While the association between MAP and Crohn’s disease remains highly controversial, the mere possibility raises concerns regarding the potential risks to human health posed by the presence of MAP in milk and beef, as well as its contamination of natural water sources [
8].
The current approach to deal Johne’s disease is very limited and has unsatisfactory results. Being unpreventable and incurable, there is a need for alternative interventions for the control, treatment, and prevention of Johne’s disease. Bacteriophages (phages) present one of the most promising new opportunities to fight infectious bacterial diseases [
9,
10]. Phages function like traditional antibiotics in a way that they exhibit powerful antimicrobial effect by infecting and lysing host bacteria. However, unlike traditional antibiotics, phages are highly selective and only kill organisms within a narrow taxonomic range. In recent years, phage therapy has gained attention as a promising treatment option for refractory, persistent, and disseminated infections in humans where antibiotics fail. Both in vivo studies and human clinical trials, including those involving pulmonary
P. aeruginosa [
11], and compassionate use in patients against pulmonary non-tuberculous mycobacterial infections [
12] indicate that phage therapy is a safe, and often more effective, alternative to conventional antibiotic treatment [
13,
14,
15,
16].
Phages have been proposed for use in animal health, including veterinary applications [
17], animal production environments [
18], and more specifically, in the dairy production chain for prophylaxis, therapeutics, environmental decontamination, and dairy product bio-preservation [
18]. Phage use in livestock has been mainly directed towards foodborne zoonotic infectious agents such as
Campylobacter,
Salmonella,
E. coli, and
Listeria. The landmark studies by Dr. Smith and his colleagues at Houghton Institute for Animal Disease Research (UK) that were carried out in young farm animals (calves, piglets, and lambs) led to a successful validation of the therapeutic use of bacteriophages against diarrheal diseases [
19,
20,
21,
22], demonstrating that severe experimental diarrhea in calves could be cured by a single dose of 10
5 phage particles administered via an oral route, and, most importantly, can be prevented by a dose as low as 100 particles [
22]. Multiple studies have explored the use of phages against
Campylobacter in the poultry industry [
23] and against
Salmonella and pathogenic
E. coli in the pig industry [
24], providing strong evidence for significant reductions in intestinal colonized pathogen counts compared to mock-treated controls without causing any collateral effects on the gut microbiome [
25].
Furthermore, phage preparations are used in food safety applications and in the animal production and processing industries to prevent pathogenic bacterial contaminations. Lytic phages effective against
Listeria monocytogenes are used in ready-to-eat meats, processed fish, cheeses, frozen vegetables, and food contact surfaces [
26]. While
Salmonella phages have been applied in chicken and pork postharvest processing,
E. coli-specific phages are used in cattle hide wash. Although phage-based products are not yet available for administration to animals, the FDA has granted provisional Generally Recognized as Safe (GRAS) status to food safety treatments against
E. coli O157:H7, Shiga-toxigenic
E. coli, Listeria,
Salmonella, and
Shigella using a single phage or phage cocktail [
27]. Phage-based products such as Agriphage in the US and Biolyse in the UK are currently on the market. Also in the US, a company called Intralytics has launched bacteriophage products for poultry health: PLSV-1™, effective against Salmonella; and INT-401™, effective against
Clostridium perfringens [
28].
The majority of mycobacteriophages have been isolated in
Mycobacterium smegmatis host [
29,
30]. However, limited studies report the discovery of phages active against MAP [
31], as isolating such phages is extremely challenging due to the complexity of working with slow-growing bacteria and their tendency to clump. Consequently, the potential use of these phages in livestock and veterinary medicine has not yet been explored. In this study, we aimed to uncover MAP phages from diverse geographical regions and to create a lytic phage bank exhibiting activity against a range of animal and human MAP isolates. Our research objectives included characterizing these phages for the host range and virulence, assessing their stability under various environmental stress conditions and in the rumen environment. Additionally, we cross-examined the selected lytic MAP phages against a wide range of fast- and slow-growing mycobacterial strains and collected data on phage receptors. The potent phages of this study can be used toward the development of highly effective phage cocktails or probiotic-like additives for prophylaxis, early therapeutic interventions, and possibly use as bio-disinfectants in dairy farms. The discovery of MAP phages creates an opportunity to develop low-cost tools for Johne’s disease control and to support the health and welfare of agricultural animals.
2. Materials and Methods
2.1. Bacterial Strains and Culture Conditions
M. avium subsp.
paratuberculosis K10 (MAP K10) was obtained from the American Type Culture Collection (ATCC). Additional MAP clinical isolates (
Table 1) were sourced from ATCC or Dr. John Bannantine at the National Centers for Animal Health, IA.
M. smegmatis mc
2 155 and
M. tuberculosis (Mtb) auxotrophic H
37R
v strains mc
2 6206 and mc
2 7901 were provided by Dr. William Jacobs, Albert Einstein College of Medicine, NY.
M. abscessus clinical strains came from the Cystic Fibrosis Research Program at National Jewish Health, CO. Non-tuberculous mycobacterial (NTM) strains were supplied by Dr. Bermudez at Oregon State University, OR.
M. smegmatis mc
2 155 was used for phage propagation, and NTM and Mtb strains were used for host range studies. All mycobacterial isolates were grown on Middlebrook 7H10 agar or in 7H9 broth with 5% OADC at 37 °C. For MAP strains, media were supplemented with 2 mg/L ferric mycobactin J.
2.2. Sample Collection and Preparation
Soil, soil–manure mix, and water samples were collected from North and South America and Asia under USDA permit P526-190513-011. Specimens were placed in 50 mL tubes filled to 25 mL. For solid samples, 20 mL of MP buffer (10 mM Tris/HCl pH 7.6, 100 mM MgSO4, 1 mM CaCl2) was added, followed by 24 h of gentle shaking. Samples were then centrifuged at 2500× g for 30 min, and the supernatant was transferred and centrifuged again. Sequential filtration through 1 µm, 0.45 µm, and 0.2 µm syringe filters followed. Water samples were similarly centrifuged and filtered. All cleared samples were spot-plated on 7H10 agar to check for contamination. Filtrates were stored at 4 °C.
2.3. Creation of MAP-Specific Phage Library
MAP K10 (ATCC BAA-968) was cultured at 37 °C on 7H10 Middlebrook agar supplemented with OADC and 2 mg/L ferric mycobactin J for 4–5 weeks. M. smegmatis mc2 155 was grown to the mid-log phase over 3 days. Prior to phage isolation, bacterial suspensions were prepared in MP buffer, sonicated, and allowed to settle for 10 min. The single-cell preparation was then used for phage isolation experiments. Approximately, 100 µL of 3 × 108 CFU (Colony Forming Units)/mL bacteria were incubated with 500 µL of cleared samples at room temperature (24 h for MAP, 30 min for M. smegmatis). Afterward, 4 mL of Top Agar was added and overlaid onto Middlebrook 7H10 agar plates (with or without Mycobactin J). Plates were incubated at 37 °C for 4–6 weeks for MAP and 3–5 days for M. smegmatis until plaques appeared. Plaques were excised, incubated in MP buffer, and re-propagated in M. smegmatis for higher titer recovery. Phages were purified using 100 kDa ultrafiltration membranes. Final phage titers were determined, and lysates (≥1010 PFU/mL) were stored at 4 °C.
Specimens not producing plaques on MAP K10 but yielding mycobacteriophages in M. smegmatis were re-tested on MAP using 1010 PFU titrations via spot testing and liquid culturing. In spot testing, 5 µL of phage lysates were applied to MAP lawns, while in liquid culturing, 50 µL of phage preparations were mixed with 10 µL MAP inoculum in 7H9 broth. Cultures were incubated for 7 days, with bacterial growth assessed via OD600 and CFU counts. The percentage reduction in bacterial growth was calculated relative to phage-free controls.
2.4. Phage Host Range in MAP Clinical Isolates
A phage library generated in MAP K10 was screened against additional clinical isolates of Johne’s and Crohn’s disease (
Table 1). The host specificity was tested using a phage spot assay with standardized MAP inoculum (3 × 10
8 CFU/mL). Two hundred microliters of inoculum were mixed with top agar and overlaid onto 7H10 agar plates supplemented with mycobactin J. Phage preparations (≥10
10 PFU) were spotted (5 µL) onto the surface, and plates were incubated for 4–8 weeks or until plaque formation. Phages producing clear plaques were considered lytic against the MAP host. The assay was conducted alongside the MAP K10 reference strain. Additionally, a liquid culture test exposed 50 µL of phage (≥10
10 PFU) to 10 µL of MAP inoculum (3 × 10
5 CFU) in 200 µL 7H9 broth. After 7 days at 37 °C, bacterial growth was recorded at OD
600, and CFU counts were determined. Bacterial reduction was compared to controls without phage, and the percentage of reduction was calculated.
2.5. The Efficiency of Plating (EOP)
The EOP was assessed for phages forming clear zones on MAP K10 across various clinical isolates. Phage preparations were standardized to 1010 PFU/mL, with 5 μL of each phage in 10–108 titrations spotted onto agar overlays containing 200 μL of MAP at 3 × 108 CFU/mL. Plates were incubated at 37 °C for 4 to 8 weeks until plaque formation was visible. EOP was calculated as the ratio of the phage titer on the clinical isolate to that on MAP K10. Phages were classified based on virulence: highly virulent (0.1 ≤ EOP ≤ 1.00), moderately virulent (0.001 < EOP < 0.1), and low virulence (EOP < 0.001).
2.6. Lytic Activity of MAP-Specific Phages Across Different Mycobacterial Species
The lytic activity of MAP-specific phages was evaluated against various mycobacterial species, including M. abscessus, M. avium subsp. hominissuis, M. chelonae, M. fortuitum, M. kansasii, M. xenopi, M. gordonae, M. mucogenicum, M. bovis BCG, and M. tuberculosis H37Ra and H37Rv auxotrophic strains. A standard plaque assay was conducted using phages at a titration of 1010 PFU. Two hundred microliters of each bacterial strain at 3 × 108 CFU/mL was overlayed with 4 mL of top agar on 7H10 Middlebrook plates, and 5 μL of phages was stamped on the surface. Plates were incubated until clear plaques formed, taking approximately 3–4 days for fast growers and up to 3 weeks for slow growers.
2.7. Phage Temperature Stability
Active phages (1010 PFU) were serially diluted and placed in 96-well PCR plates. These plates were incubated at 43 °C or 55 °C for 5 h, with duplicate plates kept at room temperature as controls. An inoculum of M. smegmatis was prepared to a concentration of 3 × 108 CFU/mL using McFarland Standard 1.0. Two hundred microliters of this inoculum was mixed with 4 mL of top agar and overlaid onto Middlebrook 7H10 plates. Five microliters of each phage dilution was stamped onto the agar surface. The plates were incubated until clear zones appeared, typically 3-4 days. Phage activity was evaluated based on the formation of clear zones relative to control plates, with lytic activity assessed by comparing phage reductions to control titration data.
2.8. Phage pH Stability
One hundred microliters of MP buffer at pH 5.0 was added to each well of a 96-well plate, followed by 10 μL of phage preparations (104–1010). The phages were incubated in this acidic environment for 24 h. An inoculum of M. smegmatis was prepared at 3 × 108 CFU/mL using McFarland Standard 1.0. Four milliliters of top agar was combined with 200 μL of the inoculum and overlaid onto Middlebrook 7H10 plates. Five microliters of the pH 5.0-exposed phages, as well as control phages incubated at pH 7.0, was spotted onto the agar surface. Plates were incubated until plaques formed. Lytic activity was determined by comparing plaque formation between the pH 5.0-exposed phages and the control phages, assessing stability and infectivity under acidic conditions.
2.9. Phage Rumen Stability
Ten microliters of phage preparations (104–1010) was placed into wells of a 96-well plate, followed by 100 μL of freshly sterilized rumen fluid. The phages were incubated in rumen fluid for 24 h at 37 °C without agitation. Two hundred microliters of M. smegmatis inoculum at 3 × 108 CFU/mL was mixed with 4 mL of top agar and overlaid on Middlebrook 7H10 plates. Five microliters of each phage preparation, including rumen-exposed and control phages, was spot-plated onto the agar. Plates were incubated until plaques appeared. Phage stability and efficacy were evaluated by comparing the plaque formation between rumen-exposed phages and control phages, determining the impact of rumen fluid on phage activity and infectivity.
2.10. Phage Stability in Milk and Colostrum
Freshly collected bovine milk and colostrum samples from Holstein Friesian cows were obtained. Phage preparations with titers ranging from 104 to 1010 PFU were dispensed in 10 μL aliquots into a 96-well plate. Each well received 100 μL of either milk or colostrum, and the plates were incubated for 24 h at 37 °C without agitation. After incubation, 200 μL of M. smegmatis inoculum (3 × 108 CFU/mL) was mixed with 4 mL of top agar and overlaid onto Middlebrook 7H10 plates. Five microliters of each phage preparation, along with control phages incubated in MP buffer, was spot-plated. Plates were incubated for 3–4 days, after which phage stability and efficacy were assessed by comparing plaque formation between milk- and colostrum-exposed phages and control phages.
2.11. Mammalian Cell Culture and Colonization/Invasion Studies
Madin–Darby bovine kidney (MDBK) epithelial cells (CCL-22) obtained from ATCC were cultivated in Dulbecco’s Modified Eagle Medium (DMEM) supplemented with 10% heat-inactivated fetal bovine serum (FBS; Gemini Bio-Products, Sacramento, CA, USA) at 37 °C in 5% CO2. The bovine mammary epithelial cell line (MAC-T) was provided by Dr. Lewis Sheffield from the Department of Dairy Science at the University of Wisconsin. MAC-T cells were cultured in DMEM supplemented with 10% heat-inactivated fetal bovine serum, 5 μg/mL insulin, and 1 μg/mL hydrocortisone. MDBK and MAC-T cell monolayers (105/well) in 96-well plates were exposed to selected phage at 1010 PFU for 30 min before adding MAP K10 inoculum (106 CFU/well) at a ratio of 10 bacteria to 1 cell. The wells were lysed at 8 h and 24 h timepoints of MAP post-infection using 0.1% Triton X-100 (Sigma-Aldrich, St. Louis, MO, USA). The lysates were serially diluted in MP buffer and plated on 7H10 agar enriched with mycobactin J to quantify surviving MAP with CFUs in comparison to the MAP growth control of non-phage treatment over time.
2.12. Scanning Electron Microscopy
Approximately 108 CFU/mL of MAP K10 strain was incubated with lytic phages (1010 PFU/mL) for 30 min or 4 h at room temperature, followed by microcentrifugation at 8000× g to pellet the bacteria. The supernatant was carefully removed, and the samples were fixed with 4% glutaraldehyde and 2% paraformaldehyde (Alfa Aesar, Ward Hill, MA, USA) for 30 min at room temperature. After fixation, the samples were microcentrifuged, the fixative was removed, and the bacterial pellets were resuspended in PBS. A 5 μL drop of each sample was placed onto a freshly glow-discharged, collodion, and carbon-coated grid. After 1 min, the grid was rinsed with 10 mM ammonium acetate and stained with 0.75% uranyl formate for 30 s. The samples were examined and imaged using a Helios 650 Ultra-Resolution Dual Beam FEG scanning transmission electron microscope at the Oregon State University Electron Microscopy Facility.
2.13. Phage DNA Preparation, Sequencing, and Genomic Analysis
Prior to DNA isolation, phage preparations were subjected to bacterial DNA and RNA removal. A 270 µL aliquot of phage samples (1010 PFU) was combined with 30 µL of DNase I 10× buffer, 1 µL of DNase I, and 1 µL of RNase. Samples were incubated at 37 °C for 1.5 h. To inactivate DNase I, 10 µL of 0.5 M EDTA was added, and the solution was incubated at 75 °C for 5 min. After eliminating host genetic material, the phage capsids were digested by adding 2.0 µL of Proteinase K (20 mg/mL) and incubating at 65 °C for 1.5 h. Phage DNAs were then purified using the GenElute Bacterial Genomic DNA Kit (Sigma-Aldrich, St. Louis, MO, USA) according to the manufacturer’s instructions. Phage DNAs were submitted to the Oregon State University Center for Quantitative Life Sciences Sequencing and Biocomputing facility and sequenced using the Illumina HiSeq 3000 system.
Gene prediction was performed using GeneMarkS and Glimmer, which provided the coordinates and FASTA amino acid sequences of predicted genes. These sequences were then compared against the NCBI BLASTp database to identify homologous genes. Full genome annotation was carried out using the DNA Master software 5.0.2 provided by the SEA-PHAGES program, which automated annotation based on BLASTn results from the NCBI database. A circular map was created using a Circular Genome Viewer (CGView) at
http://wishart.biology.ualberta.ca/cgview (accessed on 25 September 2024) [
32].
2.14. Phage Susceptibility to M. abscessus (MAB) Gene Knockout Mutants Involved in Surface-Exposed Glycolipid Transport and Synthesis
The MAB_0937c and MAB_0939 knockout mutants were screened for susceptibility via plaque formation assays using MAP phages. Inoculums of the MAB gene knockout mutants, along with the wild-type reference strain MAB 19977, were adjusted to 3 × 108 CFU/mL. Then, 200 μL aliquots of the inoculums were mixed with 4 mL of top agar and overlaid onto Middlebrook 7H10 agar plates. Five μL of each phage preparation were spot-plated onto the soft agar surface and incubated for 4–5 days or until clear plaques became visible.
2.15. Statistical Analysis
To ensure reproducibility, most experiments were conducted for three independent trials, unless stated otherwise. Statistical comparisons between experimental and control groups were performed using Student’s t-test, analyzed with Prism 10 software (GraphPad). Significance levels were denoted as * p < 0.05 and ** p < 0.01.
4. Discussion
The National Animal Health Monitoring System dairy study in 2007 revealed that 68% of U.S. dairy herds harbor
Mycobacterium avium subspecies
paratuberculosis infection in at least one cow, with nearly 100% prevalence in large herds [
34]. It is also estimated that 8% of beef cattle herds are infected with MAP. However, because entire beef herds are not routinely tested unless an individual animal tests positive for MAP, Johne’s disease is likely more widespread in beef cattle herds than is currently recognized. The current approach to deal with the disease is very limited and of unsatisfactory results. Given the unpreventable and incurable nature of Johne’s disease, there is a critical need for effective strategies for its control, prevention, and treatment. In the absence of an effective vaccine, bacteriophages offer a promising alternative to combat MAP infections. Also, traditional antimicrobial agents for large animals are limited, and long-term drug administration for mycobacterial infections is impractical both physically and economically. In contrast, low-cost MAP-specific phages offer numerous advantages [
10], including potential applications for treating both the early stages of Johne’s disease and later-stage infections in cows to prevent the spread of infection from diseased animals. Beyond treatment, phages can also be used as a ‘probiotic-like’ preparation and serve as a prophylactic intervention, administered periodically to healthy animals through water or feed additives to reduce the frequency of infections in dairy cows. This approach has the potential to make a significant impact on the industry. Due to the silent nature of MAP infections, which can take years to manifest as disease, administering phages to calves from birth via colostrum and milk could be the most effective strategy for preventing infections and reducing disease occurrence later in life. Additionally, one of the attractive characteristics of phages is their specificity, which could have a significant impact on controlling this environmental bacterium. Active phage preparations can be employed as biocontrol agents to reduce MAP infections by reducing bacterial loads in potentially contaminated dairy farm environments and lowering the overall risk of disease transmission.
The research on MAP phage identification and characterization is currently very limited [
31] and, thus, their potential applications in livestock and veterinary medicine remain largely unexplored. To highlight, the majority of fully characterized bacteriophages against mycobacteria have been discovered in
Mycobacterium smegmatis [
29,
30]. The isolation of MAP-specific phages is challenging, primarily due to the complexity of working with slow-growing bacteria and their tendency to clump. The primary goal of this research was to establish a robust phage bank targeting MAP and develop phage cocktails as cost-effective therapeutic and prophylactic interventions for Johne’s disease.
Phages that specifically infect MAP require a living host to replicate in natural environments, and MAP’s ability to survive long-term in these environments is well documented [
35]. We hypothesized that environmental samples from dairy farms with a history of MAP infection would harbor lytic phages specifically active against this pathogen. To test this, we focused on manure-exposed sites, such as water sources and decaying soil, which are likely to yield phages with lytic potential against MAP. Samples were collected from diverse geographic regions and microclimates to maximize the likelihood of isolating effective phages. We also recognized that MAP-specific phages may exist at low titers due to the pathogen’s slow growth. To address this, we screened all purified environmental samples against
M. smegmatis, a faster-growing surrogate host, to obtain phages at higher titers. These phages were then re-tested against MAP to enhance the chances of isolating specific phages. Rapid MAP-specific phage propagation and efficient production of therapeutic cocktails require the use of a fast-growing host. Leveraging
M. smegmatis ensures the quick isolation and turnover of mycobacteriophages, crucial in developing effective phage-based treatments.
M. smegmatis is a widely used model organism for studying various mycobacterial pathogens, including
M. tuberculosis and the
M. avium complex [
36,
37,
38], making it ideal for phage isolation and propagation. Importantly, global collections of mycobacterial species-specific phages have been isolated using
M. smegmatis, as all mycobacteriophages can infect this clade for reasons that remain unclear. This model organism replicates rapidly (every 1–3 h), enabling high-titer phage propagation in a cost-effective manner. Purified phage preparations from
M. smegmatis are safe for use in humans and animals. In contrast, propagating phages in pathogenic strains like MAP would be slow, uneconomical, and unsafe due to the need for extensive purification to remove pathogenic contaminants, which could provoke adverse immune reactions. Additionally,
M. smegmatis is a non-pathogenic commensal in humans and has been shown to act as a powerful cellular immune adjuvant [
39,
40,
41,
42,
43].
The direct screening of sample filtrates on the MAP K10 strain identified eight MAP-specific phages that formed clear plaques on this slow-growing pathogen. Re-testing the M. smegmatis phage library on MAP K10 revealed 15 additional phages, which, while not all forming plaques, either cleared MAP K10 cultures or significantly reduced bacterial numbers. To develop an effective intervention for Johne’s disease, it is essential to identify MAP phages with broad-spectrum activity. In total, 23 active phages found in MAP K10 were tested on five additional MAP isolates. The results show that eight phages originally isolated on MAP K10 retained plaque-forming ability, with seven additional phages exhibiting lytic activity across other MAP strains, as demonstrated by clear plaque formation and/or bacterial clearance observed using a liquid culturing method. Notably, phages capable of forming plaques suppressed bacterial growth for over two months throughout the experiment. Of the 23 phages discovered in the MAP K10 strain, most exhibited activity across various MAP clinical isolates, significantly reducing bacterial loads in vitro. Additionally, we tested these phages against a wide range of NTM species and M. tuberculosis strains, finding that some MAP phages demonstrated an extensive host range, with lytic activity against the majority of tested mycobacterial species and strains. The broad host range of this phage collection enhances its therapeutic potential, making it a promising antimicrobial tool for use across multiple species.
Orally administered phages face challenges in the bovine digestive tract due to high temperatures and acidity, which can affect their stability. The rumen, with its complex chemical composition and rich anaerobic microbiota, can also impact phage activity. For prophylactic applications in calves, phages must remain stable and virulent in milk and colostrum. In vitro results demonstrate that the majority of phages tested are stable and maintain lytic efficacy under various stress conditions, including those present in the bovine intestine, rumen, milk, and colostrum. Additionally, tissue culture studies identified robust phages that prevent MAP colonization and invasion in bovine epithelial cells by clearing or significantly reducing viable bacteria.
The diversity and versatility of phages are key advantages for therapeutic applications; however, an important aspect of designing effective phage preparations is mitigating the development of phage resistance in bacteria [
9,
44]. To achieve this, it is essential to create a cocktail of lytic phages that can bind to different host receptors and employ various mechanisms for absorption into bacterial cells. In this study, we sequenced three phages, all identified as Siphoviridae morphotypes through SEM imaging, but belonging to different genetic clusters of AC, F, and R based on comparative analysis. Moreover, building on our previous discovery of DAT/PAT trehalose polyphleates being the critical binding targets for a subset of phages in
M. abscessus [
33] and supported by findings from other studies [
44], we explored their role in MAP phage adsorption, as well. Using MAB knockout mutants lacking the MmpL10 efflux pump or polyketide synthase, we assessed susceptibility to MAP phages, distinguishing those reliant on trehalose polyphleates from those with independent lytic activity.
In this study, we successfully isolated and characterized 23 lytic phages targeting MAP. This work lays a strong foundation for expanding the MAP phage research, particularly in designing phage cocktails that could be used both to prevent and treat Johne’s disease in infected animals, aiming to reduce the infection transmission to healthy animals. The MAP-specific phage bank represents a valuable resource for cost-effective probiotic-like product development, offering targeted and sustainable solutions for one of the most persistent and costly diseases in dairy farming.